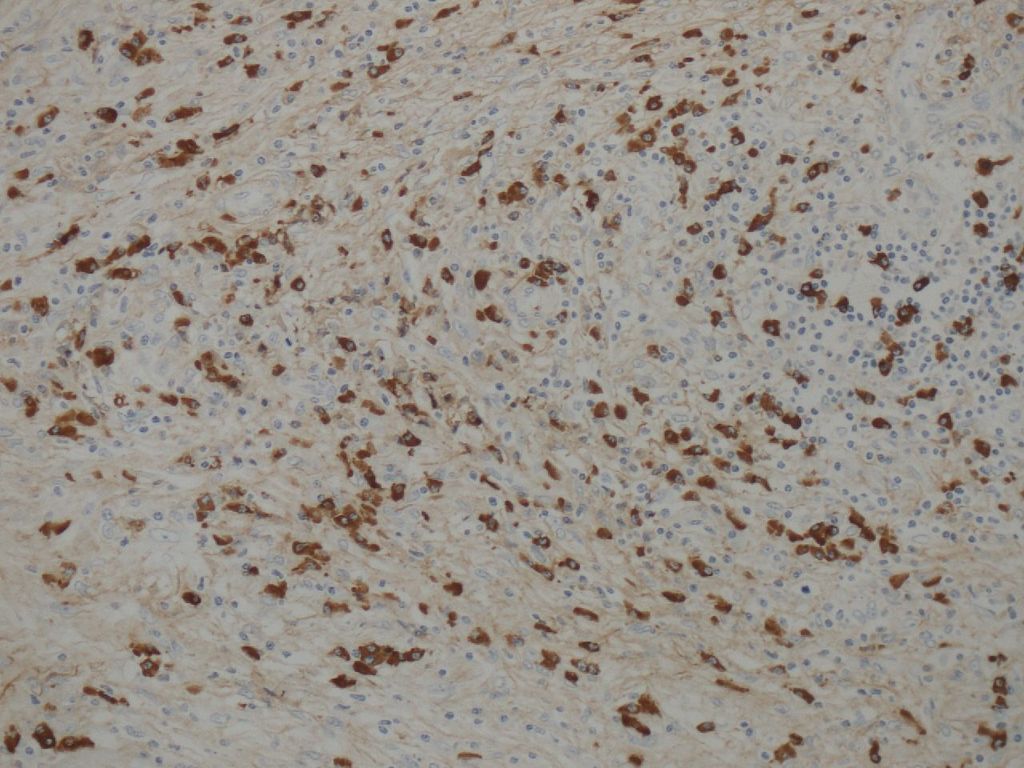

Entry Version:
Citation:
Pancreapedia: Exocrine Pancreas Knowledge Base, DOI: 10.3998/panc.2013.12
| Attachment | Size |
|---|---|
| 1.14 MB |
1. Introduction
Chronic pancreatitis, as represented by alcoholic chronic pancreatitis, is a progressive fibro-inflammatory disease of the pancreas wherein the pancreatic parenchyma is extensively and severely destroyed by fibrosis, while inflammatory cell infiltration is usually mild. Dense inflammatory cell infiltration in established chronic pancreatitis is a rare, but eye-catching finding, particularly seen in cases with tumefactive pancreatitis. Thus such cases used to be sporadically reported as a distinctive type of pancreatitis, and designated pathologically as chronic inflammatory sclerosis, lymphoplasmacytic sclerosing pancreatitis (LPSP), and non-alcoholic duct destructive chronic pancreatitis (5, 13, 23). After Yoshida et al. proposed the concept of autoimmune pancreatitis (AIP) in 1995, those pathological entities have come to be recognized as related conditions that represent the pathological features of AIP (31).
Since 2003, some groups have argued that what had been diagnosed as AIP and its related pathological entities did not constitute a single entity, but consisted of at least two different ones. A group from Mayo Clinic conducted a retrospective study with resected pancreases with a diagnosis of pancreatitis, and concluded that, in addition to a group with an entity that corresponded to LPSP, there was another designated as having idiopathic duct-centric chronic pancreatitis (IDCP) (19). Similar observations were also reported from Europe and Massachusetts General Hospital (MGH) (2, 32). AIP with and without granulocytic epithelial lesion (GEL) (terms used by the European group), and ductocentric and lobulocentric AIP (terms used by the MGH group) are considered to be identical or similar to IDCP and LPSP, respectively.
In 2001, Hamano et al. demonstrated that serum IgG4 values are elevated in AIP patients. Subsequent studies showed that affected pancreatic and non-pancreatic tissues in AIP are infiltrated by numerous IgG4-positive plasma cells (8, 9). These pivotal observations made possible the emergence of the new disease concept of what is now called IgG4-related disease (IgG4-RD) (10, 27, 29). The number of IgG4-positive plasma cells was then noted to be significantly higher in LPSP than in IDCP, leading to the realization that LPSP and IDCP are different entities, with LPSP encompassed in the spectrum of IgG4-RD (1, 33). Various clinical differences between LPSP and IDCP were also clarified (11, 22, 26). At present, LPSP and IDCP are called type 1 and type 2 AIP, respectively (1), and in the International Consensus Diagnostic Criteria (ICDC) for AIP, separate diagnostic criteria for the two subtypes have been proposed (24).
The presence of numerous IgG4-positive plasma cells is a histological feature of type 1 AIP/LPSP. However, it is noteworthy that the distinction of type 1 and type 2 AIP was clarified from a histomorphological study (19, 32). In fact, an interobserver concordance study revealed that pathologists can distinguish these two entities based on the histological findings even without immunostaining for IgG4 (34). In addition, the presence of numerous IgG4-positive cells is not specific to type 1 AIP, and can be observed in other conditions such as pancreatic abscess and cancer (28, 33). Thus, for the pathological diagnosis of type 1 AIP, the morphological features are the most important and IgG4 immunostaining is only an adjunct to diagnosis, most useful in interpreting pancreatic biopsies.
In this chapter, the unique histological features of type 1 AIP are described, with the histological features of type 2 AIP outlined later.
Pathological Characteristics of Type 1 Autoimmune Pancreatitis (LPSP)
Macroscopically, the affected pancreas is usually enlarged. The lesion can be diffuse or focal, but focal lesions are particularly prone to be resected because of the clinical difficulty in distinguishing them from pancreatic cancer. The pancreatic lobules are relatively well preserved (Figure 1), but focal destruction is not uncommon. The pancreatic duct system is open despite imaging findings suggestive of stenosis. The pancreatic parenchyma is often surrounded by a sheath of inflammation involving the peripheral parenchyma and peripancreatic adipose tissue. This feature corresponds to the radiological finding of a “capsule-like rim”.
Type 1 AIP is histologically characterized by dense lymphoplasmacytic infiltration and fibrosis. Lymphoid follicles and eosinophils are common and sometimes prominent, but neutrophils are almost never observed. In addition to these relatively nonspecific findings that may be shared with other chronic inflammatory diseases, type 1 AIP shows the following unique histological features that distinguish it from other inflammatory lesions, including type 2 AIP.

Figure 1. Macroscopic features of type 1 AIP. A portion of the pancreas is surrounded by a sheath of inflammation (white arrows). Pancreatic lobular structure is well preserved. The main pancreatic duct (blue arrow) is open, and is involved by the fibroinflammatory lession ("thickened duct wall").
Storiform Fibrosis
Storiform fibrosis is a peculiar fibrosing lesion seen in almost all cases of type 1 AIP. It is not the uniform streaming pattern commonly seen in other chronic inflammatory diseases. Instead storiform fibrosis is characterized by a haphazard and typically swirling pattern. Similar to granulation tissues changing into fibrosis over time, a series of histological differences in storiform fibrosis can be appreciated. In the early stage, a cellular component of small spindle cells, lymphocytes and plasma cells predominates, with little collagen formation (cell-rich type; Figure 2a).Collagen formation then gradually proceeds, and the cell component decreases (transitional type; Figure 2b), until finally fibrotic foci consisting mostly of collagen with a scanty cell component develop (fibrotic type; Figure 2c). A mixture of various stages may be seen in a single case.

Figure 2a. Storiform fibrosis of Type 1 AIP. Cell-rich type.

Figure 2b.Transitional type Figure 2c. Fibrotic type
Ductal Inflammation (Periductal Inflammation)
Collars with lymphoplasmacytic infiltration and/or fibrosis are seen around the pancreatic duct epithelium. Notably, neither inflammatory cell infiltration nor regressive or regenerative changes occur in the duct epithelium itself, thereby providing a useful clue to the differentiation from type 2 AIP. With all of these histological features, the ductal inflammation seen in type 1 AIP used to be called “periductal inflammation”. Ductal inflammation is easily identified in the main and interlobular pancreatic ducts, but also involves the intralobular pancreatic ducts. Two types of ductal inflammation can be recognized. The first pattern consists of a thin layer packed with lymphocytes and plasma cells just beneath the epithelium and an outer layer of fibrosis. The other pattern is composed of a thick inflammatory band with storiform fibrosis that surrounds the epithelium, giving the impression of a thickened pancreatic duct wall (Figure 3). The lumen of the ducts is narrowed and stellate-shaped due to the compression by the dense lymphoplasmacytic infiltration fibrosis. Since no structure corresponding to this kind of wall is originally present in the pancreatic ducts, it is attributed to the inflammation itself.

Figure 3. Ductal inflammation of type 1 AIP. A thick inflammatory band with storiform fibrosis surrounding the duct epithelium, giving the impression of a “thickened duct wall”. Note that the duct epithelium is intact.
Lobular Inflammation
Pancreatic lobules are almost always inflamed at least focally in type 1 AIP. With inflammation, the lobules are infiltrated by lymphocytes and plasma cells with accompanying acinar cell loss. The interlobular spaces are fibrotic. Inflamed lobules maintain their original size and shape in type 1 AIP (Figure 4) in contrast to the lobular atrophy seen in pancreatitis of other causes. The lobules also occasionally become edematous. The lobular architecture is relatively well preserved, but focal destruction of the pancreatic lobules with replacement by fibrosis is not uncommon. In the latter, areas of storiform fibrosis can be seen.

Figure 4. Lobular inflammation of type 1 AIP. Even though the lobules are inflamed and acinar cells are lost, the lobules maintain their original size and shape.
Inflammation in the Pancreatic Border, Involving Peripancreatic Adipose Tissue
The inflammation seen at the pancreatic border is most marked in type 1 AIP, giving the appearance of a shell surrounding the pancreatic parenchyma (Figure 5). This finding corresponds to the radiological finding of a capsule-like rim. Inflammation in both pancreatic parenchyma and peripancreatic adipose tissue is involved in the formation of this lesion, with the border between the two tissues being obscured. Storiform fibrosis and obliterative phlebitis are most prominent in this lesion. Inflammation does occur in the peripancreatic adipose tissue in type 1 AIP, and spreads by enclosing individual adipocytes, until fat lobules are entirely replaced by the fibroinflammatory lesions. Fat necrosis is not typically seen in Type 1 AIP.

Figure 4a. Inflammation of type 1 AIP at the pancreatic border. The pancreatic parenchyma is surrounded by a cuff of the fibroinflammatory lesion.

Figure 4b. The inflammation at the border involves both the pancreatic parenchyma (left) and peripancreatic adipose tissue (right).
Obliterative Phlebitis and Other Vascular Lesions
Inflammation seen in venules is another unique and common feature of type 1 AIP. It is characterized by lymphocyte and plasma cell infiltration from the venous wall to the lumen, culminating in venous obliteration. For this reason, this condition is called obliterative phlebitis. Similar inflammation may also be found in large veins such as the splenic and portal veins. In these instances the inflammation is limited to only a portion of the wall, and rarely results in obliteration.
In type 1 AIP all sizes of venules can be involved by obliterative phlebitis. A large number of relatively large (>100µm in diameter) venules are affected, making obliterative phlebitis perceptible even on H&E-stained slides (15). In the normal pancreas arteries and veins run in parallel; therefore, obliterative phlebitis can be suspected when there is no vein next to an artery and instead a nodular inflammatory lesion is present (Figure 6). Use of elastic stains, such as Verhoeff-van Gieson, is helpful for identifying and confirming the presence of obliterated veins, but care has to be taken to distinguish obliterative phlebitis in type 1 AIP from nonspecific fibrous venous occlusion due to venous wall damage or organized thrombosis as seen in chronic pancreatitis and pancreatic cancer (15). In this regard, it should be emphasized that the histological picture seen in obliterative phlebitis is the same as that of the surrounding inflammatory lesions, and storiform fibrosis may also be found.
Arteries and arterioles are also occasionally inflamed in type 1 AIP. The adventitia and outer layer of the media are usually involved. This finding can be designated as periarteritis/periarteriolitis in the same way as the lesions seen in the aorta and its branches (periaortitis/periarteritis) that are included in IgG4-related disease. In contrast to its venous lesions, luminal occlusion is rare in the arterial lesions. Because inflammation is marked around the arterioles in type 1 AIP, it is difficult to evaluate the arterial lesions accurately, and for this reason, this finding has not been emphasized in the previous pathological reports on type 1 AIP.

Figure 5. Obliterative phlebitis of type 1 AIP. The nodular inflammatory lesion (arrows) just next to an artery is a vein obliterated by the inflammation.
Figure 6. Abundant IgG4-positive plasma cells seen in type 1 AIP.
IgG4-positive plasma cells
Abundant IgG4-positive plasma cells are observed in type 1 AIP (Figure 7). In resected materials, the number of IgG4-positive plasma cells is usually >50 per high power field (hpf) (4). However, because it is difficult to satisfy this criterion in the biopsy diagnosis of type 1 AIP, the number of IgG4-positive plasma cells has been set at >10/hpf in the ICDC (24).
The presence of more than 10 IgG4-positive plasma cells per hpf is not specific for type 1 AIP, and can be satisfied in conditions with copious plasmacytic infiltration other than type 1 AIP, for examples in pancreatic abscess or the inflammation associated with pancreatic cancer (28, 33). In addition, more IgG4-positive plasma cells are present adjacent to lymphoid follicles. Therefore, a higher count of IgG4-positive plasma cells from those areas may be not representative. In this regard, evaluation of the IgG4/IgG-positive cell ratio is useful, the ratio being high (>40%) in type 1 AIP, while low in the other pancreatic diseases (3). However a minority of cases do not satisfy this criterion, with the IgG4/IgG-positive cell ratio being ≤40% in some type 1 AIP cases and >40% in a few with pancreatic cancer.
Thus, IgG4-immunostaining is only of limited value for the pathological diagnosis of type 1 AIP, and the importance of morphological features, notably storiform fibrosis and obliterative phlebitis, should be emphasized. The ICDC stands by this principle by specifying that a diagnosis of type 1 AIP can be established when ≥3 of the following histological features are satisfied: 1) periductal lymphoplasmacytic infiltrate without granulocytic infiltration, 2) obliterative phlebitis, 3) storiform fibrosis, and 4) abundant (>10/hpf) IgG4-positive cells (24). The same policy has been also adopted in the consensus statement on the pathology of IgG4-related disease (3).
2. Biopsy Diagnosis of Type 1 Autoimmune Pancreatitis
The distinction between AIP and pancreas cancer is vital, but is hard to make in some cases, for example in lesions with focal pancreatic enlargement and/or negative serological tests. In these situations, pancreatic biopsies may be needed to render a proper diagnosis. This trend has been driven by an advance in the technology of endoscopic ultrasound-guided fine needle aspiration (EUS-FNA) or EUS-guided Trucut biopsy (EUS-TCB).
As described earlier, the histological features of type 1 AIP are so characteristic that the diagnosis of type 1 AIP can be easily rendered based on study of the resected specimens. However, the biopsy diagnosis of type 1 AIP is challenging, because diagnostic hallmarks, such as storiform fibrosis, ductal inflammation and obliterative phlebitis, are rarely obtained or are hard to identify in tiny biopsy samples. Nevertheless, the histological diagnosis of type 1 AIP with EUS-TCB is promising, and is reported to be effective in about one half of patients (14,16). Unfortunately, however, this procedure is currently available only in a small number of institutions. Compared to EUS-TCB, the diagnostic usefulness of EUS-FNA is limited because of the smaller amount of tissue obtained, but some groups have also found this procedure to be effective (12, 14, 16).
In biopsy samples a relatively high frequency of storiform fibrosis can be seen. Obliterative phlebitis can be occasionally identified, and elastic stains are of help in this regard. Immunostaining for IgG4 is mandatory, and as described in the ICDC, the presence of more than 10 positive plasma cells per hpf is a standard for the diagnosis. Infiltration of numerous neutrophils, proliferation of plump fibroblasts and/or formation of epithelioid granulomas makes the diagnosis of type 1 AIP less likely.
So far, EUS-FNA cytology is believed to be unsatisfactory for diagnosing AIP. However, it is a highly sensitive (80-97%) and specific (82-100%) test to diagnose pancreatic cancer, and can play an important role in excluding pancreatic cancer.
3. Type 1 Autoimmune Pancreatitis and Neoplasms
IgG4-positive plasma cells may be numerous in and around cancers, and these patients may show elevated serum levels of IgG4 (7, 33). Tissue IgG4 infiltration is usually focal in the lesions, rather than diffuse like in type 1 AIP, and is not usually associated with a high IgG4/IgG-positive cell ratio (4). Inflammation is commonly seen around pancreatic cancer. Histological features included in cancer-associated inflammation are proliferation of plump fibroblasts (desmoplastic reaction), neutrophilic infiltration, and inflammatory cell infiltration with prominent edema in the lobules, all of which are distinct from type 1 AIP.
Type 1 AIP may be associated with neoplastic diseases. On rare occasions, the histological features of type 1 AIP can be seen in the setting of pancreatic cancer (17,30). IgG4-positive cells are numerous in these lesions, and even the IgG4/IgG-positive cell ratio is high. Such cases have been regarded as manifesting concomitant pancreatic cancer and type 1 AIP. From the clinical standpoint, metachronous association of pancreatic cancer after the steroid treatment of type 1 AIP has been reported (6). Extrahepatic bile duct neoplasms (a case with cancer in an early stage and another case with biliary intraepithelial neoplasia) have been reported in patients with both type 1 AIP and IgG4-related sclerosing cholangitis (20,21). A case with concomitant intraductal papillary mucinous neoplasm (IPMN) and type 1 AIP has been also reported (18). Finally, there is emerging evidence that the risk of cancer may be higher in those with AIP(25). The risk was particularly high in the first year after AIP diagnosis, and did not recur in a small number of patients after cancer treatments suggesting the possibility of a paraneoplastic syndrome.
4. Summary
Type 1 AIP is a unique form of chronic pancreatitis that has distinct histomorphology, which permits a histologic diagnosis of AIP without need for other diagnostic criteria. It is characterized by dense lymphoplasmacytic inflammation, which is nonspecific. Additional features of storiform fibrosis and obliterative phlebitis are not shared with other chronic inflammatory diseases of pancreas, and help distinguish type 1 AIP from other causes of pancreatic disease, including type 2 AIP. Finally, abundant IgG4-positive staining plasma cells is a helpful clue to diagnosis when present, but this finding is not entirelyspecific and can also be seen in pancreatic cancer.
Acknowledgment
This work was supported in part by Health and Labour Sciences Research Grants (Intractable Diseases) from the Japanese Ministry of Health, Labour and Welfare.
5. References
- Chari ST, Kloeppel G, Zhang L, Notohara K, Lerch MM, Shimosegawa T. Autoimmune Pancreatitis International Cooperative Study Group (APICS). Histopathologic and clinical subtypes of autoimmune pancreatitis: the Honolulu consensus document. Pancreas 39: 549-554, 2010. PMID: 20562576.
- Deshpande V, Chicano S, Finkelberg D, Selig MK, Mino-Kenudson M, Brugge WR, Colvin RB, Lauwers GY. Autoimmune pancreatitis: a systemic immune complex mediated disease. Am J Surg Pathol 30: 1537-1545, 2006. PMID: 17122509.
- Deshpande V, Zen Y, Chan JK, Yi EE, Sato Y, Yoshino T, Klöppel G, Heathcote JG, Khosroshahi A, Ferry JA, Aalberse RC, Bloch DB, Brugge WR, Bateman AC, Carruthers MN, Chari ST, Cheuk W, Cornell LD, Fernandez-Del Castillo C, Forcione DG, Hamilos DL, Kamisawa T, Kasashima S, Kawa S, Kawano M, Lauwers GY, Masaki Y, Nakanuma Y, Notohara K, Okazaki K, Ryu JK, Saeki T, Sahani DV, Smyrk TC, Stone JR, Takahira M, Webster GJ, Yamamoto M, Zamboni G, Umehara H, Stone JH. Consensus statement on the pathology of IgG4-related disease. Mod Pathol 25: 1181-1192, 2012. PMID: 22596100.
- Dhall D, Suriawinata AA, Tang LH, Shia J, Klimstra DS. Use of immunohistochemistry for IgG4 in the distinction of autoimmune pancreatitis from peritumoral pancreatitis. Hum Pathol 41: 643-652, 2010. PMID: 20149413.
- Ectors N, Maillet B, Aerts R, Geboes K, Donner A, Borchard F, Lankisch P, Stolte M, Lüttges J, Kremer B, Klöppel G. Non-alcoholic duct destructive chronic pancreatitis. Gut 41: 263-268, 1997. PMID: 9301509.
- Fukui T, Mitsuyama T, Takaoka M, Uchida K, Matsushita M, Okazaki K. Pancreatic cancer associated with autoimmune pancreatitis in remission. Intern Med 47: 151-155, 2008. PMID: 18239323.
- Ghazale A, Chari ST, Smyrk TC, Levy MJ, Topazian MD, Takahashi N, Clain JE, Pearson RK, Pelaez-Luna M, Petersen BT, Vege SS, Farnell MB. Value of serum IgG4 in the diagnosis of autoimmune pancreatitis and in distinguishing it from pancreatic cancer. Am J Gastroenterol 102: 1646-1653, 2007. PMID: 17555461.
- Hamano H, Kawa S, Horiuchi A, Unno H, Furuya N, Akamatsu T, Fukushima M, Nikaido T, Nakayama K, Usuda N, Kiyosawa K. High serum IgG4 concentrations in patients with sclerosing pancreatitis. N Engl J Med 344: 732-738, 2001. PMID: 11236777.
- Hamano H, Kawa S, Ochi Y, Unno H, Shiba N, Wajiki M, Nakazawa K, Shimojo H, Kiyosawa K. Hydronephrosis associated with retroperitoneal fibrosis and sclerosing pancreatitis. Lancet 359: 1403-1404, 2002. PMID: 11978339.
- Kamisawa T, Funata N, Hayashi Y, Tsuruta K, Okamoto A, Amemiya K, Egawa N, Nakajima H. Close relationship between autoimmune pancreatitis and multifocal fibrosclerosis. Gut 52: 683-687, 2003. PMID: 12692053.
- Kamisawa T, Chari ST, Giday SA, Kim MH, Chung JB, Lee KT, Werner J, Bergmann F, Lerch MM, Mayerle J, Pickartz T, Lohr M, Schneider A, Frulloni L, Webster GJ, Reddy DN, Liao WC, Wang HP, Okazaki K, Shimosegawa T, Kloeppel G, Go VL. Clinical profile of autoimmune pancreatitis and its histological subtypes: an international multicenter survey. Pancreas 40:809-814, 2011. PMID: 21747310.
- Kanno A, Ishida K, Hamada S, Fujishima F, Unno J, Kume K, Kikuta K, Hirota M, Masamune A, Satoh K, Notohara K, Shimosegawa T. Diagnosis of autoimmune pancreatitis by EUS-FNA by using a 22-gauge needle based on the International Consensus Diagnostic Criteria. Gastrointest Endosc 76: 594-602, 2012. PMID: 22898417.
- Kawaguchi K, Koike M, Tsuruta K, Okamoto A, Tabata I, Fujita N. Lymphoplasmacytic sclerosing pancreatitis with cholangitis: a variant of primary sclerosing cholangitis extensively involving pancreas. Hum Pathol 22: 387-395, 1991. PMID: 2050373.
- Levy MJ, Reddy RP, Wiersema MJ, Smyrk TC, Clain JE, Harewood GC, Pearson RK, Rajan E, Topazian MD, Yusuf TE, Chari ST, Petersen BT. EUS-guided trucut biopsy in establishing autoimmune pancreatitis as the cause of obstructive jaundice. Gastrointest Endosc 61: 467-472, 2005. PMID: 15758927.
- Miyabe K, Notohara K, Nakazawa T, Hayashi K, Naitoh I, Okumura F,Shimizu S, Yoshida M, Yamashita H, Takahashi S, Ohara H, Joh T. Histological evaluation of obliterative phlebitis for the diagnosis of autoimmune pancreatitis. J Gastroenterol (May 4, 2013). PMID: 23645070.
- Mizuno N, Bhatia V, Hosoda W, Sawaki A, Hoki N, Hara K, Takagi T, Ko SB, Yatabe Y, Goto H, Yamao K. Histological diagnosis of autoimmune pancreatitis using EUS-guided trucut biopsy: a comparison study with EUS-FNA. J Gastroenterol 44: 742-750, 2009. PMID: 19434362.
- Motosugi U, Ichikawa T, Yamaguchi H, Nakazawa T, Katoh R, Itakura J, Fujii H, Sato T, Araki T, Shimizu M. Small invasive ductal adenocarcinoma of the pancreas associated with lymphoplasmacytic sclerosing pancreatitis. Pathol Int 59: 744-747, 2009. PMID: 19788620.
- Naitoh I, Nakazawa T, Notohara K, Miyabe K, Hayashi K, Shimizu S, Kondo H, Yoshida M, Yamashita H, Umemura S, Ohara H, Joh T. Intraductal papillary mucinous neoplasm associated with autoimmune pancreatitis. Pancreas 42: 552-554, 2013. PMID: 23486370.
- Notohara K, Burgart LJ, Yadav D, Chari S, Smyrk TC. Idiopathic chronic pancreatitis with periductal lymphoplasmacytic infiltration: clinicopathologic features of 35 cases. Am J Surg Pathol 27: 1119-1127, 2003. PMID: 12883244.
- Oh HC, Kim JG, Kim JW, Lee KS, Kim MK, Chi KC, Kim YS, Kim KH. Early bile duct cancer in a background of sclerosing cholangitis and autoimmune pancreatitis. Intern Med 47: 2025-2028, 2008. PMID: 19043254.
- Ohtani H, Ishida H, Ito Y, Yamaguchi T, Koizumi M. Autoimmune pancreatitis and biliary intraepithelial neoplasia of the common bile duct: a case with diagnostically challenging but pathogenetically significant association. Pathol Int 61: 481-485, 2011. PMID: 21790863.
- Sah RP, Chari ST, Pannala R, Sugumar A, Clain JE, Levy MJ, Pearson RK, Smyrk TC, Petersen BT, Topazian MD, Takahashi N, Farnell MB, Vege SS. Differences in clinical profile and relapse rate of type 1 versus type 2 autoimmune pancreatitis. Gastroenterology 139: 140-148, 2010. PMID: 20353791.
- Sarles H, Sarles JC, Muratore R, Guien C. Chronic inflammatory sclerosis of the pancreas--an autonomous pancreatic disease? Am J Dig Dis 6: 688-698, 1961. PMID: 13746542.
- Shimosegawa T, Chari ST, Frulloni L, Kamisawa T, Kawa S, Mino-Kenudson M, Kim MH, Klöppel G, Lerch MM, Löhr M, Notohara K, Okazaki K, Schneider A, Zhang L. International Association of Pancreatology. International consensus diagnostic criteria for autoimmune pancreatitis: guidelines of the International Association of Pancreatology. Pancreas 40: 352-358, 2011. PMID: 21412117.
- Shiokawa M, Kodama Y, Yoshimura K, Kawanami C, Mimura J, Yamashita Y, Asada M, Kikuyama M, Okabe Y, Inokuma T, Ohana M, Kokuryu H, Takeda K, Tsuji Y, Minami R, Sakuma Y, Kuriyama K, Ota Y, Tanabe W, Maruno T, Kurita A, Sawai Y, Uza N, Watanabe T, Haga H, Chiba T. Risk of cancer in patients with autoimmune pancreatitis. Am J Gastroenterol 108: 610-617, 2013. PMID: 23318486.
- Song TJ, Kim JH, Kim MH, Jang JW, Park do H, Lee SS, Seo DW, Lee SK, Yu E. Comparison of clinical findings between histologically confirmed type 1 and type 2 autoimmune pancreatitis. J Gastroenterol Hepatol 27: 700-708, 2012. PMID: 21929653.
- Stone JH, Khosroshahi A, Deshpande V, Chan JK, Heathcote JG, Aalberse R, Azumi A, Bloch DB, Brugge WR, Carruthers MN, Cheuk W, Cornell L, Castillo CF, Ferry JA, Forcione D, Klöppel G, Hamilos DL, Kamisawa T, Kasashima S, Kawa S, Kawano M, Masaki Y, Notohara K, Okazaki K, Ryu JK, Saeki T, Sahani D, Sato Y, Smyrk T, Stone JR, Takahira M, Umehara H, Webster G, Yamamoto M, Yi E, Yoshino T, Zamboni G, Zen Y, Chari S. Recommendations for the nomenclature of IgG4-related disease and its individual organ system manifestations. Arthritis Rheum 64: 3061-3067, 2012. PMID: 22736240.
- Suda K, Takase M, Fukumura Y, Kashiwagi S. Pathology of autoimmune pancreatitis and tumor-forming pancreatitis. J Gastroenterol 42 Suppl 18: 22-27, 2007. PMID: 17520219.
- Umehara H, Okazaki K, Masaki Y, Kawano M, Yamamoto M, Saeki T, Matsui S, Yoshino T, Nakamura S, Kawa S, Hamano H, Kamisawa T, Shimosegawa T, Shimatsu A, Nakamura S, Ito T, Notohara K, Sumida T, Tanaka Y, Mimori T, Chiba T, Mishima M, Hibi T, Tsubouchi H, Inui K, Ohara H. Comprehensive diagnostic criteria for IgG4-related disease (IgG4-RD), 2011. Mod Rheumatol 22: 21-30, 2012. PMID: 22218969.
- Witkiewicz AK, Kennedy EP, Kennyon L, Yeo CJ, Hruban RH. Synchronous autoimmune pancreatitis and infiltrating pancreatic ductal adenocarcinoma: case report and review of the literature. Hum Pathol 39: 1548-1551, 2008. PMID: 18619645.
- Yoshida K, Toki F, Takeuchi T, Watanabe S, Shiratori K, Hayashi N. Chronic pancreatitis caused by an autoimmune abnormality. Proposal of the concept of autoimmune pancreatitis. Dig Dis Sci 40: 1561-1568, 1995. PMID: 7628283.
- Zamboni G, Lüttges J, Capelli P, Frulloni L, Cavallini G, Pederzoli P, Leins A, Longnecker D, Klöppel G. Histopathological features of diagnostic and clinical relevance in autoimmune pancreatitis: a study on 53 resection specimens and 9 biopsy specimens. Virchows Arch 445: 552-563, 2004. PMID: 15517359.
- Zhang L, Notohara K, Levy MJ, Chari ST, Smyrk TC. IgG4-positive plasma cell infiltration in the diagnosis of autoimmune pancreatitis. Mod Pathol 20: 23-28, 2007. PMID: 16980948.
- Zhang L, Chari S, Smyrk TC, Deshpande V, Klöppel G, Kojima M, Liu X, Longnecker DS, Mino-Kenudson M, Notohara K, Rodriguez-Justo M, Srivastava A, Zamboni G, Zen Y. Autoimmune pancreatitis (AIP) type 1 and type 2: an international consensus study on histopathologic diagnostic criteria. Pancreas 40: 1172-1179, 2011. PMID: 21975436.


